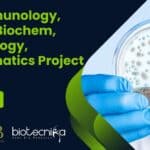
NIAB Immunology, Biotech, Biochem, Microbiology, Bioinformatics Project Jobs, Apply Online NIAB Immunology

Home Search
bioinformatics - search results
If you're not happy with the results, please do another search
10+ Project Jobs 2023 at CSIR-CCMB – Mol Bio, Bioinformatics, Biochem Apply
Project Jobs 2023 at CSIR-CCMB - Mol Bio, Bioinformatics, Biochem Apply
Project Jobs 2023 at CSIR-CCMB - Mol Bio, Bioinformatics, Biochem Apply. Project scientist jobs....
Project-JRF Job at RCB For MSc, MTech Life Sciences / Biotech / Mol Bio/...
Project-JRF Post at RCB For MSc, MTech Life Sciences / Biotech / Mol Bio/ Biochem / Microbiology / Bioinformatics/ Genomics
Project-JRF Post at RCB For...
ZSI Project Biologists Job For Zoology, Life Sciences, Bioinformatics Candidates
ZSI Project Biologists Job For Zoology, Life Sciences, Bioinformatics Candidates
ZSI Project Biologists Job For Zoology, Life Sciences, Bioinformatics Candidates. MSc Zoology, Life Sciences, Bioinformatics...
NIAB Bioinformatics & Computational Biology Project Associate Recruitment, Apply Online
NIAB Bioinformatics & Computational Biology Project Associate Recruitment, Apply Online
NIAB Bioinformatics & Computational Biology Project Associate Recruitment, Apply Online. National Institute of Animal Biotechnology...
CSIR-TKDL Bioinformatics & Biological Sciences Project Jobs, Apply Online
CSIR-TKDL Bioinformatics & Biological Sciences Project Jobs, Apply Online
CSIR-TKDL Bioinformatics & Biological Sciences Project Jobs, Apply Online. MSc / PhD Biological Sciences/ Bioinformatics Project...
Application Scientist – Computational Biology, Bioinformatics Job At Prescience Insilico Pvt. Ltd
Prescience Insilico Pvt. Ltd Hiring. Computational Biology job opening 2023, Bioinformatics Job opening 2023, Application Scientist post vacancy at Prescience Insilico Pvt. Ltd. Bioinformatics...
Shiv Nadar PhD Life Sciences/ Bioinformatics Admissions 2023 – Apply Now
Shiv Nadar PhD Admissions 2023 For PhD Life Sciences/ Bioinformatics
Shiv Nadar PhD Admissions 2023 For PhD Life Sciences/ Bioinformatics. Ph.D. Admissions Announcement: Monsoon 2023....
You Asked & We Listened – Bioinformatics Summer Internship 2023 New Dates & Timing!
Bioinformatics Summer Internship 2023 New Dates & Timing!
Join the revolution of data-driven discovery with our bioinformatics internship
Learn from the best in the industry!
30 Days...
NIAB Immunology, Biotech, Biochem, Microbiology, Bioinformatics Project Jobs, Apply Online
NIAB Immunology, Biotech, Biochem, Microbiology, Bioinformatics Project Jobs, Apply Online
NIAB Immunology, Biotech, Biochem, Microbiology, Bioinformatics Project Jobs, Apply Online. National Institute of Animal Biotechnology...
Biotecnika Times Newsletter 10.04.2023 Himedia 0-1 Year Exp Job, THSTI Bioinformatics Jobs, Gene Mapping...
Biotecnika Times Newsletter 10.04.2023 Himedia 0-1 Year Exp Job, THSTI Bioinformatics Jobs, Gene Mapping Notes + Much More
HIMEDIA Bioinformatics Analyst Job For Candidates With...
THSTI Bioinformatics, Genomics & Life Sciences Research Scientist Job With Rs. 75,000 pm Pay
THSTI Bioinformatics Research, Genomics & Life Sciences Scientist Job With Rs. 75,000 pm Pay
THSTI Bioinformatics Research, Genomics & Life Sciences Scientist Job With Rs....
HIMEDIA Bioinformatics Analyst Job For Candidates With 0-1 Year Exp
HIMEDIA Bioinformatics Analyst Job For Candidates With 0-1 Year Exp
Are you a recent MSc graduate in Bioinformatics, Biotech, or Life Sciences with experience in...
Bioinformatics Project Scientist Job at IBSE: Centre for Integrative Biology and Systems medicinE
Bioinformatics Project Scientist Job at IBSE: Centre for Integrative Biology and Systems medicinE
Bioinformatics Project Scientist Job at IBSE: Centre for Integrative Biology and Systems...
National Institute of Immunology Project Associate Jobs For Bioinformatics, Life Sciences & More
NII Bioinformatics, Biology Project Job Openings - Applications Invited
NII Bioinformatics, Biology Project Job Openings - Applications Invited. MSc, MTech Biological Sciences, Biotech, Biophysics, Bioinformatics,...
CDFD Bioinformatics, Mol Bio, Cell Biology, Biotech Research Job Opening, Applications Invited
CDFD Bioinformatics, Mol Bio, Cell Biology, Biotech Research Job Opening, Applications Invited
CDFD Bioinformatics, Mol Bio, Cell Biology, Biotech Research Job Opening, Applications Invited. Bioinformatics,...